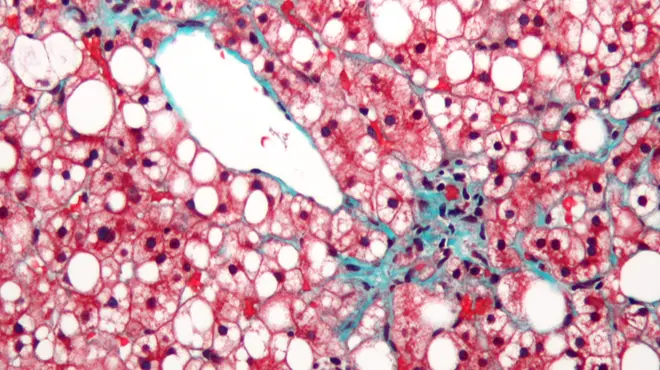

Elizabeth Dougherty
is a science writer at the Novartis Institutes for BioMedical Research.
icon
-
Story
 Eye on patients, mind on innovation
Eye on patients, mind on innovation -
Story
 Bringing virtual reality to the lab
Bringing virtual reality to the lab -
Story
 Going global to meet local needs in China
Going global to meet local needs in China -
Story
 Loss of friend to liver cancer sharpens focus on experimental therapy
Loss of friend to liver cancer sharpens focus on experimental therapy -
Story
 Killing three diseases with one stone in the lab
Killing three diseases with one stone in the lab -
Story
 Experimental treatment clears malaria infections in small clinical study
Experimental treatment clears malaria infections in small clinical study -
Story
 The Evolution of a Scientist
The Evolution of a Scientist -
Story
 Reaping cancer clues from the blood
Reaping cancer clues from the blood -
Story
 Tackling the common denominator in liver disease
Tackling the common denominator in liver disease -
Story
 Factory foreman keeps liver’s line workers on task
Factory foreman keeps liver’s line workers on task -
Story
Leveraging the liver’s ability to heal scarred tissue
Leveraging the liver’s ability to heal scarred tissue -
Story
 Novartis and Pfizer join forces to upend oncology dogma
Novartis and Pfizer join forces to upend oncology dogma